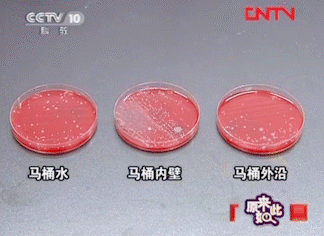

对很多人来说,做家务都是一件麻烦事,每个人都不喜欢做家务。
但在生活中,家务活是无法避免的。每个人都需要做家务,既然不可避开,那就只有享受或者采用快捷方法。
比如刷碗令很多人头疼,还好现在很多家庭都配了洗碗机,让不少「劳动人民」解放了双手。
如果说还有比洗碗更恼火的事情,那一定是刷马桶!

就连拥有 20 年家政经验的老阿姨都说宁洗 100 次碗,也不愿刷 1 次马桶。
刷过马桶的人都懂,这件事它不仅是看着恶心闻着还臭,当你闻到臭味儿的时候代表自己的鼻子已经吸入了不少分解出来的细小粪便分子颗粒。
有时候就算隔着 3 层口罩都扛不住!刷完感觉脱了手套都还觉得手脏!
但是,刷马桶这事儿它又无可逃避,我们每人每天上 8 次厕所,一年下来怎么也得 2920 次。
如果不刷马桶,要不了多久,家里的厕所就布满了脏污。

还有,除了肉眼可见的脏,每次冲完马桶看似水流已经将污物一起卷走了。
但其实有权威研究曾指出,即便在刚刚冲完的马桶内壁上,病菌数量仍高达 10 万个。

央视一档叫《原来如此》的节目就曾经做过关于马桶细菌测试的实验。
结果发现:马桶内壁的细菌要比马桶外沿和马桶蓄水坑里的还要多
而且,细菌是可以被冲水时产生的强大气流带到空气中到处乱飘的!

难免了这些细菌会空降在你的毛巾、牙刷、厕纸、衣服、化妆品上
再加上卫生间相对而言比较潮湿不通风,这些你天天亲密接触的东西就成了细菌的温床。
所以,马桶必须得花点心思好好清洁!
为了能清理干净马桶,小编家各种洁厕用品没少买,洁厕灵、蓝泡泡……
但是,这些普通的清洁蓝色小块使用起来真的是槽点满满:
✘使用周期短
✘残渣挂壁严重
✘尿垢难以清洗
✘存放易受潮变质

想要每天都用清爽无菌的马桶,还不想浪费太多时间在刷马桶这件事上?
除了聘请专门的家政阿姨代劳,还有一个省时省力还省钱的好方法!
今天给大家推荐这款「马桶自动清洁神器」【 inwejia 新一代魔瓶清洁凝胶】

INWEJIA, 一个追求按需购买的日本人气家居清洁品牌,提供上百种家居清洁组合方案。

因为设计大方、简单好用、性价比极高。成为日本知名「主妇帮手」
这款常居畅销榜的魔瓶清洁凝胶,更是他们家的明星产品。放一瓶平均可以冲 1588 次左右,半年换一次。
而且,它的抑菌率高达99.9%。在日本可是非常受欢迎的!
文末有福利哦
▲点击上图立即购买▲
作为用了 N 多款马桶清洁剂的小编,亲自替大家试用了,只是把魔瓶放在水箱里就不管了。

但是,接下去的日子里,每次一冲厕所它都比家政阿姨更贴心的全面发挥「威力」,把马桶壁冲得干干净净~

单单就这一条,已经足够小编这样的懒人下单了。
除了省时省事省钱,它还:
1、颜值高,日系简约风,秒杀普通洁厕产品
2、浓缩凝胶配方,微孔自动释放,告别刷马桶
3、使用周期长,一瓶可用半年无需更换
4、99.9% 抑菌率,不挂壁无残留,轻松去污

升级版「活氧清洁」
清洁成分是普通洁厕宝的 5 倍
日常家用的蓝泡泡小编也用过,冲不干净不说还会有残留挂壁等现象
而且 1 颗顶多只能用 3-5 天,太不经用了。

因为蓝泡泡的成分大部分由各种清洁剂、香精、染料构成,所以成本低且不耐用。

而魔瓶清洁凝胶在普通洁厕产品的技术上做了升级改造,加入了 50% 天然植物表面活性剂。
这种成分遇水溶解后很快就会扩散到整个水面,能在短时间内瓦解马桶中的碱性污渍,清洁力比普通洁厕宝高 5 倍。

另外,魔瓶还采用了新型凝胶缓释技术。每次在水箱冲水上水的过程中就是一次压力的缓释。
当水箱中的水加满以后,就不再释放,能做到每次均匀冲洗,不挂壁。
不会像市面上产品前几次特别浓,颜色特别深,用多了还担心不健康不环保等顾虑。
这魔瓶不仅每次冲洗都能高效去污,还会在马桶的陶瓷釉面形成一层保护膜,防止便、尿渍附着堆积。

以前刷马桶,刷了半天又累又臭都没能去掉污渍,现在啥也不做就能轻松除垢,而且还不仅仅是那种肉眼可见的干净!
文末有福利哦
▲点击上图立即购买▲
除菌抑菌率高达到 99.9%
能够有效预防疾病
魔瓶成分中的植物有机酸能在迅速消灭马桶病菌。每一次冲洗马桶,都相当于一次严格的灭菌作业。
经过专业机构检测,抑菌率高达 99.9%!还能 72 小时长效抑菌~

不仅马桶中除菌效果好,还能随水流到管道、死角,切断病菌滋生的途径。
像马桶箱用久了也是藏污纳垢之地,但常常被我们忽略。而有了魔瓶后就能把病菌污垢都消灭,长期使用,马桶箱也变成新的了。

绿色环保不污染操作简单
一瓶足够用半年
市面上的洁厕灵,近两成产品总酸度超标,你平时在用的可能是不合格的产品
大家可要提高警惕了

而 inwejia 魔瓶采用天然植物配方用着更安全,每次冲洗完,还会散发出一股淡淡的香气。
小孩孕妇都能放心使用~

最后,魔瓶的外观也实力圈粉。比起其他洁厕用品,Tiffany蓝真的很小清新。

操作起来也很简单,只需撕下侧面的贴纸,把顶部的盖子全部取下,放入水箱内静置 5 分钟后就能使用了!

一瓶能冲洗 1588 次左右。长达半年,用完了也方便更换

所有使用过魔瓶的客户也都是满满的好评:









